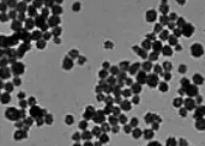
image.png

过氧化钙纳米颗粒,Calcium Peroxide Nanoparticles,CaO2 NPs
Calcium Peroxide Nanoparticles
询价
5mg
起订
10mg
起订
50mg
起订
陕西 更新日期:2026-03-07
产品详情:
- 中文名称:
- 过氧化钙纳米颗粒
- 英文名称:
- Calcium Peroxide Nanoparticles
- 品牌:
- xingbieak
- 产地:
- 陕西西安
- 保存条件:
- -20℃
- 纯度规格:
- 99%
- 产品类别:
- 微球
- 是否进口:
- 否
- 用途:
- 科研
- 产品规格:
- mg
- 别名:
- CaO2 NPs,Nano-CaO2
- 存储时间:
- 一年
- 销售范围:
- 全国
公司简介
陕西星贝爱科生物科技有限责任公司是西北一家从事经营进口科研试剂销售公司,科研试剂主要涉及生命科学、医
学及药学,生命科学试剂供应商之一
| 成立日期 | (4年) |
| 注册资本 | 100万元 |
| 员工人数 | 1-10人 |
| 年营业额 | ¥ 100万以内 |
| 经营模式 | 贸易,试剂,定制 |
| 主营行业 | 生物材料,纳米材料,高分子化学,合成材料,通用试剂 |
过氧化钙纳米颗粒相关厂家报价
-
- 过氧化锌纳米颗粒 ZnO2 Nanoparticles
- 西安瑞禧生物科技有限公司 VIP
- 2026-02-28
- 询价
-
- lImagion Biosystems纳米颗粒
- 维百奥(北京)生物科技有限公司 VIP
- 2026-03-02
- 询价
-
- 银纳米颗粒
- 海泰纳鑫科技(成都)有限公司
- 2025-10-29
- 询价
-
- 过氧化钙纳米颗粒 CaO2 Nanoparticles
- 西安瑞禧生物科技有限公司 VIP
- 2026-02-28
- 询价